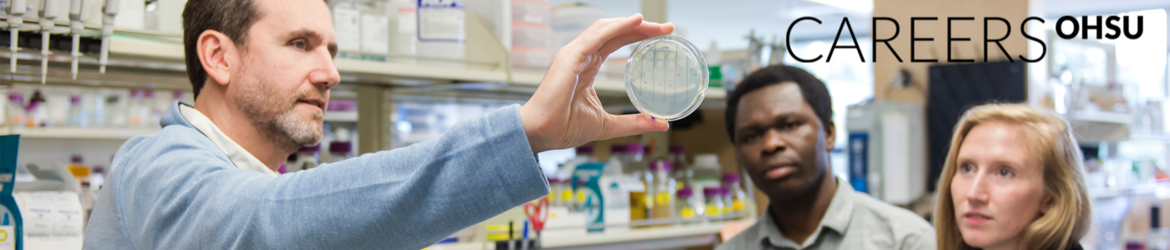

Oregon Health & Science University is a nationally prominent research university and Oregon’s only public academic health center. It serves patients throughout the region with a Level 1 trauma center and nationally recognized Doernbecher Children’s Hospital.
OHSU operates dental, medical, nursing and pharmacy schools that rank high both in research funding and in meeting the university’s social mission. OHSU’s Knight Cancer Institute helped pioneer personalized medicine through a discovery that identified how to shut down cells that enable cancer to grow without harming healthy ones. OHSU Brain Institute scientists are nationally recognized for discoveries that have led to a better understanding of Alzheimer’s disease and new treatments for Parkinson’s disease, multiple sclerosis and stroke. OHSU’s Casey Eye Institute is a global leader in ophthalmic imaging, and in clinical trials related to eye disease.
OHSU treats the most complex health needs in the region, makes discoveries that save lives and educates next-generation health pros.









